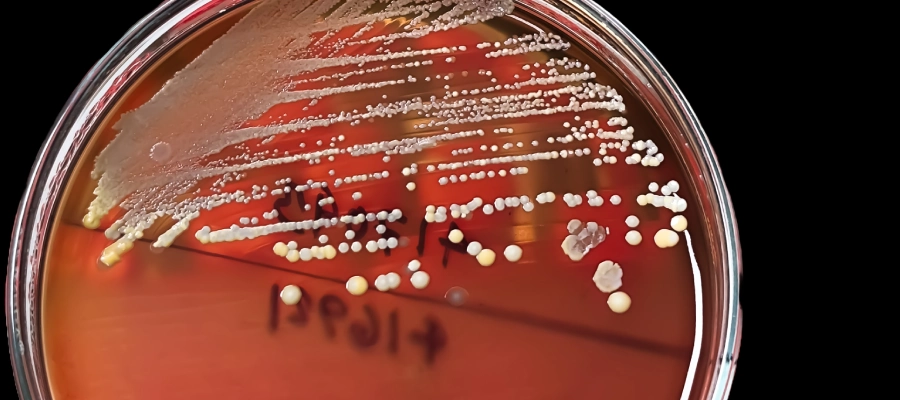

Hemoliz, kırmızı kan hücrelerinin (eritrositlerin) yıkılmasıyla ortaya çıkan bir durumdur. Bu süreçte hücrelerin içeriğindeki bilirubin gibi maddeler kana salınır. Normalde vücuttaki dengeyi koruyan bu süreç, aşırı olduğunda anemi, sarılık ve diğer kan hastalıklarına yol açabilir. Hemoliz indeksi, hemolizin kanda ne düzeyde olduğunu gösterir ve genellikle normal aralığın dışına çıkmamalıdır. Hemoliz yüksekliği, altta yatan ciddi bir sağlık sorununun işareti olabilir.
Hemoliz Nedir?
Hemoliz, vücutta kırmızı kan hücrelerinin (eritrositlerin) parçalanmasıyla gerçekleşen doğal bir süreçtir. Normal şartlarda, yaşlanan eritrositler dalakta parçalanarak yenilenir. Ancak bu sürecin hızlanması veya kontrolsüz bir şekilde artması, kanda bilirubin seviyesinin yükselmesine ve hemolitik anemi gibi sağlık sorunlarına neden olabilir.
Hemoliz, aşırı gerçekleştiğinde vücutta anemi, sarılık ve yorgunluk gibi belirtilerle kendini gösterebilir. Ayrıca, hemoliz indeksi adı verilen bir testle ölçülerek normal değerlerin dışına çıkıp çıkmadığı tespit edilebilir. Hemolizin nedenleri genetik hastalıklardan bağışıklık sistemi sorunlarına kadar değişiklik gösterebilir. Bu durumun teşhis ve tedavisi için uzman bir hekim tarafından değerlendirilmesi önem taşır.
Hemoliz Değeri Kaç Olmalı?
Hemoliz, kırmızı kan hücrelerinin (eritrositlerin) parçalanmasıyla oluşan bir süreçtir. Bu durumun değerlendirilmesinde hemoliz indeksi kullanılır. Hemoliz değerlendirmesi genellikle LDH (Laktat Dehidrogenaz) ve bilirubin seviyeleri gibi diğer laboratuvar testleriyle yapılır.
Bu değerlerin üzerinde çıkan sonuçlar, kanda hemoliz yüksekliği olduğunu gösterebilir ve hemolitik anemi gibi durumlara işaret edebilir. Bu nedenle, anormal sonuçlar elde edildiğinde bir sağlık profesyoneline danışmak önemlidir.
Hemolizin Belirtileri Nelerdir?
Hemoliz, vücuttaki kırmızı kan hücrelerinin anormal bir şekilde yıkılmasıyla ortaya çıkar ve farklı belirtilerle kendini gösterebilir. Bu durum, hafif bir yorgunluktan ciddi sağlık sorunlarına kadar geniş bir yelpazede semptomlara yol açabilir. Anemi, sarılık ve genel halsizlik, hemolizle ilişkilendirilen yaygın belirtiler arasındadır. Altta yatan nedenlere bağlı olarak, belirtiler şiddetli veya hafif olabilir.
Anemi ve Yorgunluk
Hemolitik anemi, hemolizin en sık görülen sonuçlarından biridir ve genellikle aşağıdaki belirtilerle fark edilir:
- Sürekli yorgunluk ve enerji eksikliği
- Soluk ten rengi
- Hızlı kalp atışı veya çarpıntı
- Nefes darlığı, özellikle fiziksel aktivite sırasında
Sarılık ve Cilt Belirtileri
Hemoliz sırasında bilirubin seviyelerinin yükselmesi, ciltte ve gözlerde belirgin değişikliklere neden olabilir, bunlar:
- Sararmış cilt ve göz akları (sarılık)
- Kaşıntılı ve kuru cilt
- İdrarın koyulaşması veya turuncu renk alması
Diğer Belirtiler
Hemoliz bazı durumlarda, sistemik etkiler yaratarak farklı belirtilerle kendini gösterebilir. Bu belirtiler genellikle kırmızı kan hücresi yıkımının derecesine ve altta yatan nedene bağlıdır. Hemolizin diğer belirtileri şunları içerebilir:
- Karın ağrısı veya hassasiyet
- Dalakta büyüme (splenomegali)
- Ateş ve enfeksiyonlara yatkınlık
- İdrarda kan görülmesi

Hemoliz Neden Olur?
Hemoliz, kırmızı kan hücrelerinin (eritrositlerin) yıkım hızının artması sonucu meydana gelir ve birçok farklı nedene bağlı olarak ortaya çıkabilir. Hemoliz, genetik yatkınlıklardan çevresel faktörlere kadar değişkenlik gösterebilir. Kalıtsal faktörler, doğuştan gelen hastalıklar nedeniyle eritrositlerin yapısal bozukluklarına neden olabilirken, edinilmiş nedenler enfeksiyonlar, bağışıklık sistemi bozuklukları veya ilaç kullanımı gibi sonradan gelişen durumları içerir. Nedenlerin doğru tespiti, hemolizin etkili tedavisi için büyük önem taşır.
Kalıtsal Faktörler
Kalıtsal nedenlerle hemoliz geliştiğinde, genetik mutasyonlar eritrositlerin yapısını veya dayanıklılığını olumsuz etkileyebilir. Yaygın kalıtsal nedenler şunlardır:
- Orak hücreli anemi: Kırmızı kan hücrelerinin şekil bozukluğu nedeniyle erken yıkımı.
- G6PD eksikliği: Eritrositlerin belirli enzimlerin eksikliği nedeniyle dayanıklılığını kaybetmesi.
- Talasemi: Hemoglobin üretimindeki genetik kusurlar nedeniyle kırmızı kan hücrelerinin yıkılması.
- Sferositoz: Hücre zarındaki yapısal bozukluklar nedeniyle eritrositlerin erken parçalanması.
Edinilmiş Nedenler
Edinilmiş nedenler genellikle çevresel faktörler veya sonradan gelişen sağlık sorunlarıyla ilişkilidir. Bu tür nedenler şunları içerebilir:
- Bağışıklık sistemi bozuklukları: Otoimmün hastalıklar eritrositleri hedef alabilir.
- Enfeksiyonlar: Bazı viral veya bakteriyel enfeksiyonlar hemolize neden olabilir.
- İlaçlar: Bazı ilaçların yan etkileri, eritrositlerin yıkımını hızlandırabilir.
- Zehirlenme: Kurşun gibi toksik maddelere maruz kalma hemolizi tetikleyebilir.
- Yapay kalp kapakçıkları: Mekanik hasar nedeniyle kırmızı kan hücreleri parçalanabilir.
Hemoliz Tanısı Nasıl Konur?
Hemoliz tanısı, kişinin yaşadığı belirtilerle birlikte kan testleri ve görüntüleme yöntemleriyle konur. Tanı sürecinde, eritrositlerin yıkım hızını ve buna bağlı vücut değişikliklerini değerlendirmek için kapsamlı bir inceleme yapılır. Laboratuvar testleri, bilirubin düzeyi, hemoliz indeksi ve diğer biyokimyasal parametreleri belirlerken, görüntüleme yöntemleri dalak veya karaciğer gibi organların durumunu değerlendirmeye yardımcı olur.
Laboratuvar Testleri
Hemoliz tanısında laboratuvar testleri, kırmızı kan hücrelerinin parçalanma oranını belirlemede ilk adımdır. Bu testler genellikle şu parametreleri ölçer:
- Tam kan sayımı (CBC): Hemolitik anemi ve düşük eritrosit seviyelerini gösterir.
- Bilirubin testi: Hemoliz sırasında yükselen bilirubin seviyelerini değerlendirir.
- LDH (Laktat Dehidrogenaz): Yükselmesi, eritrosit yıkımıyla ilişkilidir.
- Haptoglobin seviyesi: Düşük haptoglobin, hemolizin önemli bir göstergesidir.
- Periferik yayma: Kırmızı kan hücrelerinin şekil ve büyüklüğündeki değişiklikleri inceler.
Görüntüleme Yöntemleri
Bazı durumlarda hemoliz, altta yatan nedenleri saptamak için görüntüleme teknikleriyle desteklenir. Kullanılan yöntemler şunlardır:
- Ultrasonografi: Dalak büyümesi (splenomegali) veya karaciğer sorunlarını tespit eder.
- Manyetik Rezonans Görüntüleme (MR): Organlarda anormal demir birikimini değerlendirmek için kullanılır.
- BT (Bilgisayarlı Tomografi): Kan akışını ve organ hasarını analiz eder.
- Kemik İliği Aspirasyonu: Gerekli durumlarda, kan hücrelerinin üretimini incelemek için yapılır.
Hemoliz ile İlgili Sıkça Sorulan Sorular
Hemoliz hangi hastalıklara yol açabilir?
Aşırı hemoliz, vücutta anemi, sarılık ve bilirubin seviyelerinin yükselmesine neden olabilir. Bu durumlar, hemolitik anemi gibi kan hastalıklarına yol açabilir. Ayrıca, kanda hemoliz yüksekliği organ hasarına ve diğer sistemik problemlere sebep olabilir.
Hemoliz nasıl teşhis edilir?
Hemoliz teşhisi için kan testleri yapılır. Bu testler arasında tam kan sayımı, bilirubin seviyeleri, LDH ve haptoglobin düzeyleri bulunur. Ayrıca, hemoliz indeksi de değerlendirilir. Gerekli durumlarda, altta yatan nedenleri belirlemek için ek testler uygulanabilir.
Hemoliz tedavi edilmezse ne olur?
Tedavi edilmeyen hemoliz, vücutta anemi, sarılık ve organ hasarına yol açabilir. Uzun vadede, bu durumlar ciddi sağlık sorunlarına neden olabilir. Bu nedenle, hemoliz belirtileri fark edildiğinde bir sağlık profesyoneline başvurmak önemlidir.
Hemoliz genetik midir?
Hemoliz, hem genetik hem de çevresel faktörlere bağlı olarak gelişebilir. Orak hücreli anemi ve talasemi gibi genetik hastalıklar, kalıtsal hemolize neden olabilir. Ayrıca, bazı enzim eksiklikleri de genetik geçiş gösterebilir.
Hemoliz çocuklarda görülür mü?
Evet, hemoliz çocuklarda da görülebilir. Özellikle genetik yatkınlık veya doğuştan gelen enzim eksiklikleri olan çocuklarda hemoliz riski artar. Çocuklarda hemoliz belirtileri fark edildiğinde, erken teşhis ve tedavi için doktora başvurulmalıdır.
Hemoliz önlenebilir mi?
Kalıtsal nedenlere bağlı hemolizi tamamen önlemek mümkün olmasa da, tetikleyici faktörlerden kaçınarak hemoliz ataklarının sıklığı ve şiddeti azaltılabilir. Örneğin, enfeksiyonlardan korunma, uygun ilaç kullanımı ve düzenli sağlık kontrolleri önemlidir.
Hemoliz hamilelikte risk oluşturur mu?
Hamilelikte hemoliz, hem anne hem de bebek için risk oluşturabilir. Hemolitik anemi, hamilelik sürecini olumsuz etkileyebilir. Bu nedenle, hamilelik öncesi ve sırasında düzenli kontrollerle hemoliz riski değerlendirilmelidir.



















